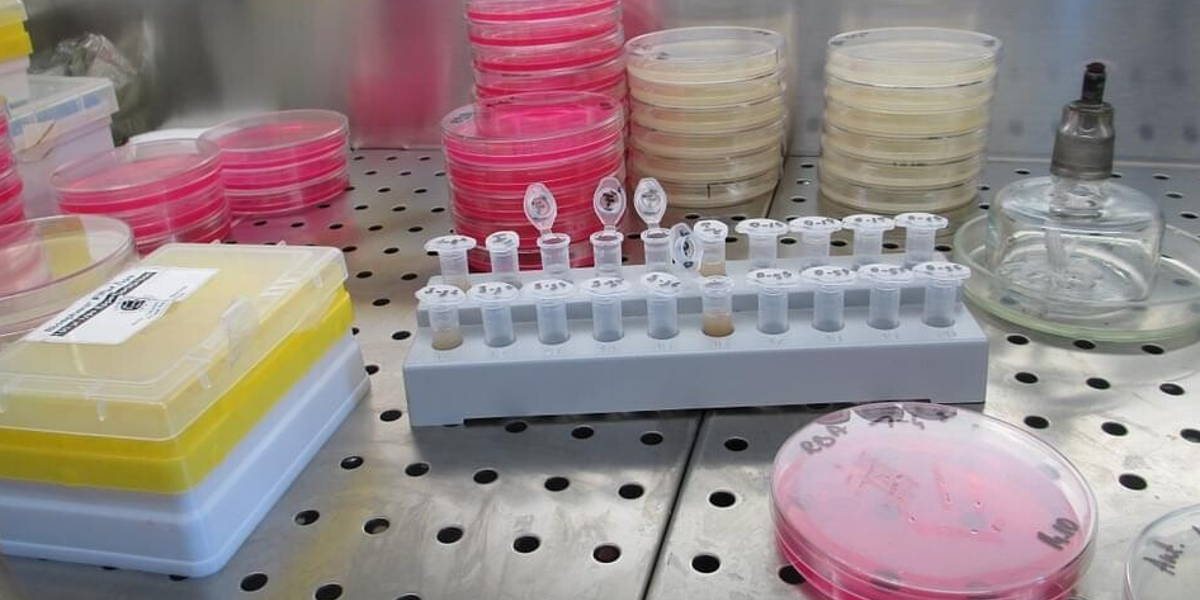
Laboratorium-2

Een buiten het lichaam gekweekt mini-orgaan kan helpen om de effectiviteit van medicatie bij individuele patiënten met taaislijmziekte (CF) te voorspellen. Dat hebben onderzoekers van het UMC Utrecht onlangs kunnen aantonen. Hiermee komt maatwerk in medicatie ofwel personalised medicine dichterbij. Artsen krijgen namelijk de mogelijkheid om een medicijn voor te schrijven dat het beste aanslaat bij zijn patiënt.
Mini-organen – ook wel organoïden genoemd– worden opgekweekt in het laboratorium met behulp van stamcellen. In Nederland gebeurt dit steeds vaker. Zo is het Maastricht UMC+ samen met MAASTRO clinic, een onderzoek begonnen naar de combinatie van protonentherapie met andere behandelingen (zoals chemo- en immunotherapie). Daarvoor maken de wetenschappers van beide instellingen gebruik van gekweekte mini-orgaantje.
Gepersonaliseerde medicatie
Eén van de potentiële voordelen van deze mini-organen is volgens de onderzoekers van het UMC Utrecht dat je er medicatie op kunt testen, zonder problemen voor, of effect op de patiënt zelf. ‘Zo’n mini-orgaan kan een arts vertellen welke medicatie bij welke patiënt aanslaat, en welke niet. Op deze manier is het mogelijk om gepersonaliseerde medicijnen te ontwikkelen’, aldus een nieuwsbericht van het universitair ziekenhuis.
In het kader van de studie zijn drie verschillende medicijnen bij 24 patiënten met verschillende vormen van taaislijmziekte onderzocht. De effecten van deze medicijnen konden duidelijk worden gekoppeld aan de eerdere effecten van deze medicatie op de mini-darmen.
“We hadden al eerder bij twee patiënten laten zien dat een mini-orgaan kan worden gebruikt om medicatie voor te schrijven”, vertelt onderzoeker Jeffrey Beekman - die samen met kinderlongarts Kors van der Ent het onderzoek leidde. “Dit onderzoek laat voor het eerst zien hoe betrouwbaar voorspellingen kunnen zijn voor de individuele patiënt.”
Horizon 2020-studie
Doordat de mini-organen in een biobank worden opgeslagen, konden de onderzoekers bestaande en toekomstige geneesmiddelen in het laboratorium aan individuele patiënten koppelen. Het UMC Utrecht leidt sinds januari 2018 een grote (EU) Horizon 2020-studie waarin dit voor 500 patiënten met de meest zeldzame vormen van taaislijmziekte verder onderzocht wordt. Kors van der Ent hierover: “Dit is voor het eerst dat we de voorspellende waarde van mini-organen voor individuele patiënten hebben gemeten.”
Taaislijmziekte is een ernstige en ongeneeslijke ziekte. De erfelijke ziekte komt in Nederland bij zo'n 1.500 mensen voor – waaronder bij meer dan 800 volwassenen. De afgelopen jaren is er steeds meer mogelijk geworden om de symptomen van taaislijmziekte te bestrijden en het ziekteproces te vertragen. De kwaliteit van leven bij patiënten met taaislijmziekte is dan ook al een stuk beter dan vroeger. De levensverwachting ligt gemiddeld tussen de 35 en 40 jaar.
De resultaten van het onderzoek zijn deze week gepubliceerd in Cell Reports.